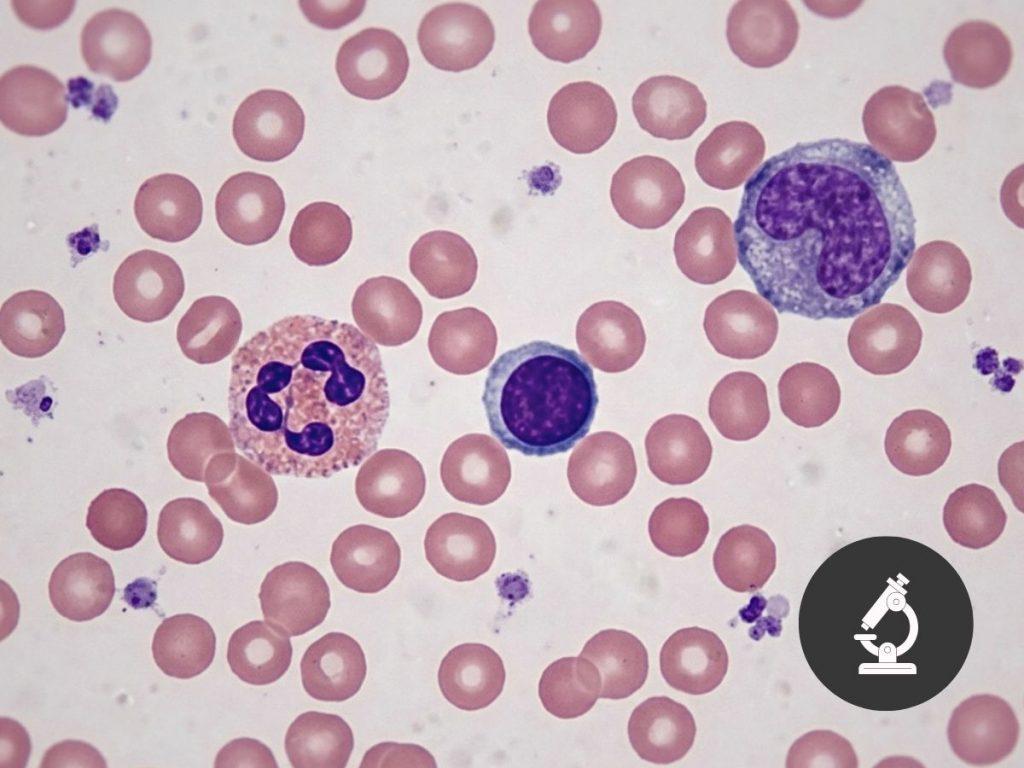

Viele Menschen denken, ein kleines oder großes Blutbild sei eine Art Gesundheits-Komplettcheck. Genau das ist einer der häufigsten Denkfehler. Hier erfährst du verständlich, was im Blutbild wirklich gemessen wird, wo der Unterschied zwischen kleinem und großem Blutbild liegt – und warum ein unauffälliger Befund noch lange nicht heißt, dass alles untersucht wurde.
Von Dr. Maria Folk, Ärztin
Stand: 09.04.2026 · Medizinisch eingeordnet von Dr. Maria Folk
Was ist der Unterschied und was bedeuten deine Blutwerte wirklich?
Du liest auf deinem Laborbefund Begriffe wie Erythrozyten, Leukozyten, Hämoglobin oder Hämatokrit oder kryptische Abkürzungen. Vielleicht ist irgendwo ein Sternchen und eine rote Markierung oder es ist laut Arzt „alles unauffällig“. Und trotzdem hast du vielleicht gar nicht wirklich verstanden, was da überhaupt gemessen wurde.
So geht es vielen Menschen. Das Blutbild gehört zu den häufigsten Blutuntersuchungen überhaupt und trotzdem wissen die wenigsten, was diese Werte wirklich bedeuten. Viele denken bei einem kleinen oder großen Blutbild an so eine Art Rundum-Check. Einmal Blut abnehmen und dann sieht man schon, ob z.B. alles mit deiner Schilddrüse und Leber in bester Ordnung ist. Oder ob deine Vitamine, deine Eisenwerte oder dein Blutzucker unauffällig sind. Genau DAS ist aber nicht der Fall.
Der Begriff „Blutbild“ klingt leider größer, als das, was tatsächlich gemessen wird. Denn ein Blutbild schaut in erster Linie auf deine Blutzellen: rote und weiße Blutkörperchen und Blutplättchen. Es ist somit ein erster Blick ins Innere, aber eben kein kompletter Gesundheitscheck.
In diesem Artikel bekommst du eine verständliche Einordnung, was das kleine und das große Blutbild eigentlich sind, welche Werte dazugehören, wo der Unterschied liegt und warum ein unauffälliges Blutbild noch lange nicht bedeutet, dass alles optimal ist.
Auf einen Blick
- Das kleine Blutbild gehört zu den häufigsten Standard-Blutuntersuchungen
- Es zeigt v.a. die Zellbestandteile deines Blutes
- Dazu gehören Erythrozyten, Leukozyten, Thrombozyten, Hämoglobin und Hämatokrit
- Das große Blutbild ist im Grunde das kleine Blutbild plus die genauere Aufschlüsselung der weißen Blutkörperchen (Untergruppen)
- Schilddrüsenwerte, Leberwerte, Blutzucker, Vitamine und Mineralstoffe sind nicht (!) Teil des Blutbilds
- Ein unauffälliges Blutbild kann beruhigend sein, ersetzt aber keinen tieferen Blick auf Stoffwechsel, Hormone und Nährstoffversorgung
Was ein Blutbild überhaupt ist
Wenn in der Praxis von einem Blutbild gesprochen wird, denken viele automatisch an eine große Rundum-Blutkontrolle. Genau hier liegt aber der Denkfehler, denn das Blutbild ist kein umfassendes Laborpanel und auch kein kompletter Gesundheitscheck. Es schaut v.a. auf die Zellen deines Blutes und nicht auf Vitamine, Mineralstoffe, Hormone, Schilddrüse, Leber, Nieren oder deinen Blutzucker. Das ist wichtig zu verstehen, weil viele Menschen den Satz „Ihr Blutbild ist in Ordnung“ innerlich mit „gesundheitlich ist alles wunderbar“ gleichsetzen. So einfach ist es aber nicht. Ein Blutbild kann wertvolle Hinweise geben, zum Beispiel auf Blutarmut, Infekte, Entzündungen oder Auffälligkeiten bei der Blutbildung. Aber es zeigt eben nur einen Ausschnitt deiner inneren Welt und nicht das komplette Bild.
Das kleine Blutbild: die Basis
Zum kleinen Blutbild gehören vor allem diese Werte:
- Erythrozyten – rote Blutkörperchen
- Hämoglobin – roter Blutfarbstoff
- Hämatokrit – Anteil der Blutzellen am Blutvolumen
- Leukozyten – weiße Blutkörperchen
- Thrombozyten – Blutplättchen

Je nach Labor tauchen zusätzlich oft noch Werte wie MCV, MCH und MCHC auf. Diese sogenannten Erythrozyten-Indizes helfen dabei, die roten Blutkörperchen genauer nach Farbe und Größe einzuordnen. Weil genau diese Abkürzungen für viele Menschen ein riesiges Fragezeichen sind und sehr häufig gesucht werden, bekommen sie bei mir einen eigenen Artikel.
Was die einzelnen Werte grob zeigen können
Die Erythrozyten sind deine roten Blutkörperchen. Ihre wichtigste Aufgabe ist der Sauerstofftransport. Wenn hier etwas nicht stimmt, kann sich das zum Beispiel in Müdigkeit, Blässe, verminderter Belastbarkeit oder Kurzatmigkeit zeigen. Gerade deshalb lohnt sich bei auffälligen Blutwerten im Blutbild auch oft ein Blick auf Eisen, Vitamin B12 und Folsäure.
Die Leukozyten sind die weißen Blutkörperchen und gehören zu deinem Immunsystem. Sie helfen dir, Krankheitserreger abzuwehren und auf Entzündungen zu reagieren. Wenn sie erhöht oder erniedrigt sind, kann das viele Ursachen haben (von einem banalen Infekt über Stress bis hin zu Entzündungen). Ein einzelner Leukozytenwert sagt aber noch nicht automatisch, was genau dahintersteckt.
Die Thrombozyten sind deine Blutplättchen. Sie spielen eine zentrale Rolle bei der Blutgerinnung. Wenn du dich schneidest, helfen sie mit, dass die Blutung gestoppt wird.
Das Hämoglobin ist der rote Blutfarbstoff deiner Erythrozyten. Er bindet Sauerstoff und transportiert ihn durch den Körper. Wenn das Hämoglobin niedrig ist, denken viele sofort an Eisenmangel. Das kann sein, muss aber nicht die einzige Erklärung sein. Auch Blutverluste (z.B. starke Menstruation oder nach Operationen), Vitamin-B12-Mangel, Folsäuremangel oder andere Störungen der Blutbildung kommen infrage.
Der Hämatokrit zeigt vereinfacht gesagt, wie viel deines Blutes aus Zellen besteht und wie viel aus Flüssigkeit. Auch dieser Wert wird erst im Zusammenhang mit den anderen wirklich interessant.
Was ist dann das große Blutbild?
Das große Blutbild ist kein komplett anderer Test, sondern im Grunde das kleine Blutbild plus eine genauere Aufschlüsselung der weißen Blutkörperchen. Man spricht hier auch vom Differenzialblutbild.
Der Unterschied liegt also nicht darin, dass plötzlich neue Körpersysteme untersucht werden, sondern darin, dass die Leukozyten noch feiner betrachtet werden (Untergruppen). Dabei schaut man auf:
- Lymphozyten
- Monozyten
- Granulozyten
- neutrophile Granulozyten
- eosinophile Granulozyten
- basophile Granulozyten
Das klingt erst einmal technisch, bedeutet aber im Grunde nur: Welche Untergruppen deiner Immunzellen sind wie stark vertreten? Genau das kann helfen, Infekte, allergische Reaktionen, Entzündungen oder bestimmte immunologische Prozesse besser einzuordnen. Wenn du dir also merken willst, was der Unterschied zwischen kleinem und großem Blutbild ist, dann im Kern das hier: Das große Blutbild ist das kleine Blutbild plus die Untergruppen deiner weißen Blutkörperchen (Leukozyten).

Was das Blutbild kann und was nicht
Das Blutbild ist ein wichtiger erster Blick auf dein Blut, aber es ist kein kompletter Gesundheitscheck. Es kann Hinweise geben auf Blutarmut (Anämie), Infekte, Entzündungen, Blutverluste oder Auffälligkeiten bei der Blutbildung. Das ist absolut wertvoll.
Was es aber nicht kann, ist dir ein vollständiges Bild deiner Gesundheit geben, denn im Blutbild findest du keine Schilddrüsenwerte, keine Leberwerte, keine Nierenwerte, keinen Blutzucker und auch keine Vitamine oder Mineralstoffe. Genau deshalb kann dein Blutbild normal aussehen und du fühlst dich trotzdem müde, erschöpft oder nicht richtig in deiner Kraft.
Und hier entsteht in der Praxis oft unnötige Verwirrung. Viele Menschen hören nach der Blutabnahme, dass das Blutbild „unauffällig“ sei und gehen dann davon aus, dass damit automatisch auch Vitamine, Eisen, Leber, Schilddrüse oder Blutzucker mitbeurteilt wurden. Das ist aber nur dann der Fall, wenn diese Werte zusätzlich mitbestimmt wurden. Ein normales Blutbild heißt also nicht automatisch, dass „alles untersucht“ wurde. Das ist einer der wichtigsten Punkte überhaupt.
Wann das kleine oder große Blutbild besonders hilfreich ist
Das Blutbild ist besonders dann spannend, wenn es um grundlegende Fragen geht wie:
- Gibt es Hinweise auf eine Blutarmut (Anämie)?
- Gibt es Zeichen für einen Infekt oder eine Entzündung?
- Gibt es Auffälligkeiten bei der Blutgerinnung?
- Ist die Blutbildung grundsätzlich unauffällig?
Gerade bei Symptomen wie Müdigkeit, Blässe, Infektanfälligkeit, Schwäche oder ungewöhnlicher Erschöpfung ist es oft einer der ersten sinnvollen Schritte. Gleichzeitig sollte man sich aber nicht zu früh mit einem „alles normal“ zufriedengeben, wenn das Körpergefühl etwas anderes sagt. Wenn zum Beispiel Hämoglobin und Erythrozyten noch im Referenzbereich liegen, heißt das nicht automatisch, dass die Eisenspeicher gut gefüllt sind. Genau dafür braucht es dann oft zusätzliche Werte wie Ferritin oder Transferrin. Und wenn Leukozyten auffällig sind, kann je nach Situation ein großes Blutbild oder ein Entzündungswert wie CRP sinnvoll sein.
Was du bei einem auffälligen Blutbild tun solltest
Wenn einzelne Werte im Blutbild auffällig sind, lohnt es sich auf das Muster und den Zusammenhang zu schauen.
Wichtige Fragen können dann sein:
- Sind eher die roten oder weißen Blutkörperchen auffällig?
- Passt das Bild eher zu Eisenmangel, Blutverlust, Infekt oder Entzündung?
- Gibt es Symptome, die dazu passen?
- Welche Blutwerte wären als Nächstes sinnvoll?
- Ist das eine einmalige Auffälligkeit oder ein Verlauf / Muster?
Was du aus deinem Blutbild wirklich mitnehmen kannst
Das kleine und große Blutbild sind keine Geheimcodes und auch keine kompletten Gesundheitschecks. Sie sind ein erster, sinnvoller Blick auf dein Blut und können wertvolle Hinweise geben. Gleichzeitig ist es wichtig zu wissen, was darin nicht enthalten ist.
Wenn du deine Blutwerte wirklich verstehen willst, reicht es nicht, nur auf eine Markierung oder einen Referenzbereich (Normwerte) zu schauen. Es geht darum, zu erkennen, was dieser Befund zeigt, wo seine Grenzen sind und wann weitere Werte sinnvoll sein können.
Genau dafür habe ich mein Buch Blutgeflüster geschrieben. Das Buch hilft dir, Laborwerte in Alltagssprache zu verstehen, Zusammenhänge zu erkennen und deine Befunde mit mehr Ruhe und Klarheit einzuordnen.
Medizinischer Hinweis
Ein einzelner Laborwert erklärt selten das ganze Bild. Die Inhalte auf dieser Seite helfen dir, Zusammenhänge besser zu verstehen. Sie ersetzen keine individuelle ärztliche Beratung, Diagnostik oder Behandlung. Triff medizinische Entscheidungen immer gemeinsam mit einer qualifizierten medizinischen Fachperson.
FAQ: Kleines und großes Blutbild
Hier findest du kurze, verständliche Antworten auf häufige Fragen zu kleinem und großem Blutbild, typischen Missverständnissen und sinnvollen nächsten Schritten.
Nein. Genau das ist ein ganz typischer Denkfehler. Ein kleines oder großes Blutbild ist kein kompletter Gesundheitscheck, sondern schaut in erster Linie auf deine Blutzellen. Werte wie Schilddrüse, Leber, Nieren, Blutzucker, Ferritin, Vitamin B12 oder Vitamin D sind darin nicht enthalten, sondern müssen immer extra bestimmt werden.
Das kleine Blutbild zeigt die wichtigsten Grundwerte deiner Blutzellen. Das große Blutbild enthält zusätzlich die genauere Aufschlüsselung der weißen Blutkörperchen, also das Differenzialblutbild. Der Unterschied liegt also bei den Untergruppen der Leukozyten.
Im kleinen Blutbild werden v.a. Erythrozyten, Leukozyten, Thrombozyten, Hämoglobin und Hämatokrit bestimmt. Es ist also ein grundlegender Blick auf dein Blut.
Das ist absolut möglich. Ein normales kleines Blutbild bedeutet nicht automatisch, dass dein Stoffwechsel, deine Schilddrüse, deine Eisenspeicher oder deine Vitaminversorgung optimal sind. Gerade Ferritin (Speichereisen), Vitamin B12, Folsäure, Blutzucker oder Schilddrüsenwerte können auffällig sein, obwohl das Blutbild selbst unauffällig ist.
Erhöhte Leukozyten oder auffällige Untergruppen können zum Beispiel bei Infekten, Entzündungen, Stress, allergischen Reaktionen oder anderen Immunprozessen auftreten. Ein einzelner Wert reicht aber nicht aus, um die Ursache sicher zu benennen. Dafür braucht es immer den Zusammenhang und eine ärztliche Einordnung.
Ja, diese Erythrozyten-Indizes gehören inhaltlich zum kleinen Blutbild beziehungsweise zur genaueren Einordnung der roten Blutkörperchen. Sie helfen u.a. dabei, Blutarmut besser zu differenzieren und können Hinweise auf Eisenmangel, Vitamin-B12-Mangel oder Folsäuremangel geben. Genau deshalb bekommen sie bei mir einen eigenen Artikel.
Für das Blutbild allein ist Nüchternheit nicht immer zwingend notwendig. Wenn aber gleichzeitig weitere Werte wie Blutzucker, Blutfette oder Leberwerte mitbestimmt werden, ist nüchtern die bessere Wahl.
Das hängt stark von deinen Symptomen ab. Häufig sind je nach Beschwerdebild zusätzliche Werte wie Ferritin, Transferrin, CRP, Vitamin B12, Folsäure, Schilddrüsenwerte oder Blutzucker sinnvoll. Ein unauffälliges Blutbild ist oft ein guter erster Schritt – aber nicht automatisch das Ende der Abklärung.
CRP kann vor allem dann sinnvoll sein, wenn Leukozyten auffällig sind oder der Verdacht auf einen Infekt beziehungsweise eine Entzündung im Raum steht. Das Blutbild zeigt, dass im Zellbild etwas auffällig sein kann. CRP kann helfen, das Entzündungsgeschehen besser mit einzuordnen.
Verwandte Themen
Blutwerte stehen selten für sich allein. Gerade wenn dein Blutbild unauffällig ist, du dich aber trotzdem müde, erschöpft oder nicht richtig in deiner Kraft fühlst, lohnt sich oft der Blick auf angrenzende Laborwerte. Die folgenden Seiten helfen dir dabei, typische Zusammenhänge besser zu verstehen und den nächsten sinnvollen Schritt einzuordnen.
- Schilddrüsenwerte besser einordnen
- Blutzucker, HbA1c und Insulin besser verstehen
- Ferritin, Eisen & Eisenmangel verstehen
- Blutwerte besser verstehen
Quellen und weiterführende Literatur
Die medizinische Einordnung dieser Seite stützt sich auf ausgewählte Fachquellen und wissenschaftliche Grundlagen zum Thema Blutbild.
- CLSI. Defining, Establishing, and Verifying Reference Intervals in the Clinical Laboratory; Approved Guideline – Third Edition (EP28-A3c/C28-A3). Clinical and Laboratory Standards Institute.
- Badrick T, El-Khoury JM, Theodorsson E. Laboratory reference intervals – history and modern approaches for improved utility. Scand J Clin Lab Invest. 2025;85(4):229-241. doi: 10.1080/00365513.2025.2512995.
- Corrons JLV, Casafont LB, Frasnedo EF. Concise review: how do red blood cells born, live, and die? Ann Hematol. 2021;100(10):2425-2433. doi: 10.1007/s00277-021-04575-z.
- Cappellini MD, Motta I. Anemia in Clinical Practice-Definition and Classification: Does Hemoglobin Change With Aging? Semin Hematol. 2015;52(4):261-269. doi: 10.1053/j.seminhematol.2015.07.006.
- Kaferle J, Strzoda CE. Evaluation of macrocytosis. Am Fam Physician. 2009;79(3):203-208.
- Christoffersson G, Phillipson M. The neutrophil: one cell on many missions or many cells with different agendas? Cell Tissue Res. 2018;371(3):415-423. doi: 10.1007/s00441-017-2780-z.
